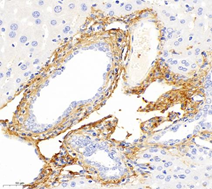
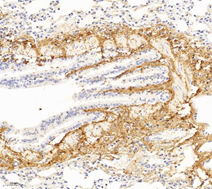

Collagen I
- 100ul
Product Information
Description | Collagen I rabbit polyclonal |
Protein full name | Collagen alpha-1(I) chain |
Synonyms | COL1A1, EDSC, OI1, OI2, OI3, OI4, collagen type I alpha 1, collagen type I alpha 1 chain |
Immunogen | Recombinant protein corresponding to Mouse COL1A1 |
Isotype | IgG |
Purity | Affinity purification |
Subcellular location | |
Uniprot ID |
Applications
Applications | Species | Dilution | Positive Tissue |
IHC | Human, Mouse, Rat | 1: 800-1: 1600 | para-cancer kidney, skin, fibrosis liver, lung |
IF | Human, Mouse, Rat | 1: 800-1: 1600 | atherosclerotic vessels, liver, lung, para-cancer lung |
Background
This gene encodes the pro-alpha1 chains of type I collagen whose triple helix comprises two alpha1 chains and one alpha2 chain. Type I is a fibril-forming collagen found in most connective tissues and is abundant in bone, cornea, dermis and tendon. Mutations in this gene are associated with osteogenesis imperfecta types I-IV, Ehlers-Danlos syndrome type VIIA, Ehlers-Danlos syndrome Classical type, Caffey Disease and idiopathic osteoporosis. Reciprocal translocations between chromosomes 17 and 22, where this gene and the gene for platelet-derived growth factor beta are located, are associated with a particular type of skin tumor called dermatofibrosarcoma protuberans, resulting from unregulated expression of the growth factor.
Images
| Immunohistochemistry analysis of paraffin-embedded human para-cancer kidney using Collagen I (GB11022-3) at dilution of 1: 1600 |
| Immunohistochemistry analysis of paraffin-embedded mouse skin using Collagen I (GB11022-3) at dilution of 1: 1600 |
| Immunohistochemistry analysis of paraffin-embedded mouse fibrosis liver using Collagen I (GB11022-3) at dilution of 1: 1600 |
| Immunohistochemistry analysis of paraffin-embedded rat fibrosis liver using Collagen I (GB11022-3) at dilution of 1: 1600 |
| Immunohistochemistry analysis of paraffin-embedded rat lung using Collagen I (GB11022-3) at dilution of 1: 1600 |
| Immunofluorescent analysis of paraformaldehyde-fixed mouse lung using Collagen I (GB11022-3) at dilution of 1: 1600 |
| Immunofluorescent analysis of paraformaldehyde-fixed mouse atherosclerotic vessels using Collagen I (GB11022-3) at dilution of 1: 1600 |
| Immunofluorescent analysis of paraformaldehyde-fixed rat liver using Collagen I (GB11022-3) at dilution of 1: 1600 |
| Immunofluorescent analysis of paraformaldehyde-fixed rat lung using Collagen I (GB11022-3) at dilution of 1: 1600 |
| Immunofluorescent analysis of paraformaldehyde-fixed human para-cancer lung using COLIII (GB11629) (green) + Collagen I (GB11022-3) (red) + Actin (GB111364) (yellow) + CD31 (GB12064) (orange) at dilution of 1: 1600 |
| Immunofluorescent analysis of paraformaldehyde-fixed mouse BDL model liver using Collagen I (GB11022-3) at dilution of 1: 1600 |
Storage
| Storage | Store at -20 ℃ for one year. Avoid repeated freeze/ thaw cycles. |
| Storage Buffer | PBS with 0.02% sodium azide, 100 μg/ml BSA and 50% glycerol. |
NOTE:
1.This product is intended for research only.
2.This product is recommended to dilute with the Primary Antibody Dilution Buffer (G2025).
| 货号 | 名称 | 规格 | 价格 | 操作 |
|---|
| 货号 | 名称 | 规格 | 价格 | 操作 |
|---|